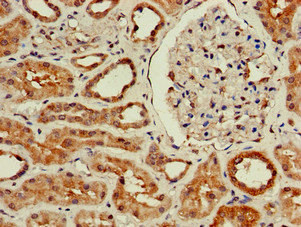

WISP3 Antibody
-
中文名稱:WISP3兔多克隆抗體
-
貨號(hào):CSB-PA026121LA01HU
-
規(guī)格:¥440
-
圖片:
-
Western Blot
Positive WB detected in: HepG2 whole cell lysate, Rat heart tissue, Mouse heart tissue
All lanes: WISP3 antibody at 3.5µg/ml
Secondary
Goat polyclonal to rabbit IgG at 1/50000 dilution
Predicted band size: 40, 42 kDa
Observed band size: 40 kDa -
Immunohistochemistry of paraffin-embedded human kidney tissue using CSB-PA026121LA01HU at dilution of 1:100
-
Immunohistochemistry of paraffin-embedded human liver cancer using CSB-PA026121LA01HU at dilution of 1:100
-
-
其他:
產(chǎn)品詳情
-
產(chǎn)品描述:
CUSABIO uses the recombinant fusion protein containing a sequence corresponding to amino acids 201-372 of human WISP3 as the immunogen to immunize the rabbit to produce the anti-WISP3 antibody. This WISP3 polyclonal antibody is an unconjugated IgG. It is reactive with human, mouse, and rat samples. It is purified by protein G and reaches up to 95% in purity. It has been validated for WB, ELISA, and IHC applications. Its target protein WISP3 is a secreted cysteine-rich matricellular protein involved in chondrogenesis, osteogenesis, and tumorigenesis. The suppression of WISP3 expression has been shown to promote cell growth, invasion, and metastasis and protect cells from apoptosis and anoikis.
-
產(chǎn)品名稱:Rabbit anti-Homo sapiens (Human) WISP3 Polyclonal antibody
-
Uniprot No.:
-
基因名:WISP3
-
別名:CCN 6 antibody; CCN family member 6 antibody; CCN6 antibody; CYR61 antibody; LIBC antibody; Lost in inflammatory breast cancer tumor suppressor protein antibody; MGC125987 antibody; MGC125988 antibody; MGC125989 antibody; OTTHUMP00000040421 antibody; PPAC antibody; PPD antibody; UNQ462/PRO790/PRO956 antibody; WISP 3 antibody; WISP-3 antibody; WISP3 antibody; WISP3_HUMAN antibody; WNT 1 inducible signaling pathway protein 3 antibody; Wnt 1 signaling pathway protein 3 antibody; WNT1 inducible signaling pathway protein 3 antibody; WNT1 inducible signaling pathway protein 3 precursor antibody; WNT1-inducible-signaling pathway protein 3 antibody
-
宿主:Rabbit
-
反應(yīng)種屬:Human, Mouse, Rat
-
免疫原:Recombinant Human WNT1-inducible-signaling pathway protein 3 protein (201-372AA)
-
免疫原種屬:Homo sapiens (Human)
-
標(biāo)記方式:Non-conjugated
本頁面中的產(chǎn)品,WISP3 Antibody (CSB-PA026121LA01HU),的標(biāo)記方式是Non-conjugated。對(duì)于WISP3 Antibody,我們還提供其他標(biāo)記。見下表:
-
克隆類型:Polyclonal
-
抗體亞型:IgG
-
純化方式:>95%, Protein G purified
-
濃度:It differs from different batches. Please contact us to confirm it.
-
保存緩沖液:Preservative: 0.03% Proclin 300
Constituents: 50% Glycerol, 0.01M PBS, pH 7.4 -
產(chǎn)品提供形式:Liquid
-
應(yīng)用范圍:ELISA, WB, IHC
-
推薦稀釋比:
Application Recommended Dilution WB 1:500-1:5000 IHC 1:20-1:200 -
Protocols:
-
儲(chǔ)存條件:Upon receipt, store at -20°C or -80°C. Avoid repeated freeze.
-
貨期:Basically, we can dispatch the products out in 1-3 working days after receiving your orders. Delivery time maybe differs from different purchasing way or location, please kindly consult your local distributors for specific delivery time.
-
用途:For Research Use Only. Not for use in diagnostic or therapeutic procedures.
相關(guān)產(chǎn)品
靶點(diǎn)詳情
-
功能:Plays a role in mitochondrial electron transport and mitochondrial respiration. Through its regulation of the mitochondrial function may play a role in normal postnatal skeletal growth and cartilage homeostasis.
-
基因功能參考文獻(xiàn):
- WISP-3/CCN6 has a role in inhibiting apoptosis by regulating caspase pathway after hyperoxia in lung epithelial cells PMID: 29920361
- WISP3 gene was associated with developmental dysplasia of the hip (DDH) in Chinese Han population. GGCGG haplotype might be a biomarker for DDH. PMID: 29680248
- analysis of WISP3 mutations causing progressive pseudorheumatoid dysplasia in Jammu and Kashmir-India PMID: 27291587
- These results demonstrate that CCN6 regulates epithelial and mesenchymal states transition and tumor initiating cells programs in breast cancer PMID: 26933820
- two WISP3 mutations have been identified in two affected siblings by targeted NGS, thus permitting the clinical diagnosis of PPD. This case supports the utility of NGS in the genetic characterization of skeletal dysplasias, which in turn may aid their clinical care, permit predictive screening, and to provide genetic counselling to families. PMID: 26991965
- CCN6 acts as a molecular brake, which is appropriately balanced by Nrf2, in regulating mitochondrial function. PMID: 27252383
- Studies indicate that the CYR61 CTGF NOV matricellular proteins (CCN family of proteins) comprises the members CCN1, CCN2, CCN3, CCN4, CCN5 and CCN6 and have been identified in various types of cancer. PMID: 26498181
- WISP3 harbored not only frameshift mutation but also mutational intratumoral heterogeneity and loss of expression, which together might play a role in tumorigenesis of GC and CRC with MSI-H by inhibiting tumor suppressor functions of WISP3. PMID: 26997449
- WISP3 variant leads to the diagnosis of SEDT-PA. PMID: 26493744
- Novel and recurrent mutations in WISP3 and an atypical phenotype have been described in Indian families with progressive pseudorheumatoid dysplasia. PMID: 25988854
- A novel mutation c.667T>G (p.Cys223Gly) and the c.857C>G (p.Ser286*) mutation were detected in three Chinese patients with PPD. PMID: 25738435
- This study identified 3 different WISP3 mutations in 2 unrelated Chinese families with spondyloepiphyseal dysplasia tarda with progressive arthropathy. PMID: 25553839
- Suggest WISP3-Wnt/beta-catenin axis may have role in regulating gastric cancer cell proliferation and metastasis. PMID: 25400723
- Novel C223G and C252X mutations in exon 4 of the WISP3 gene are responsible for progressive pseudorheumatoid dysplasia in Chinese patients. PMID: 25794430
- Results are indicative of an operational WISP3-IGF1 regulatory loop whereby WISP3 preserves cartilage integrity by restricting IGF1-mediated hypertrophic changes in chondrocytes, at least partly, upon interaction with IGF1. PMID: 23424195
- A report on 11 different homozygous mutations and one instance of compound heterozygosity in the WISP3 gene in patients with progressive pseudorheumatoid dysplasia. PMID: 22987568
- These results reveal a novel function of the matricellular protein CCN6 and establish a mechanistic link between CCN6 and TbetaRIII in maintaining acinar organization in the breast. PMID: 23226100
- Mutation analysis of WISP3 allowed the confirmation of the diagnosis in 63 out of 64 typical cases of progressive pseudorheumatoid dysplasia. PMID: 22791401
- The data presented in this study reveal that CCN6 downregulation disrupts acinar morphogenesis and promotes invasion of mammary epithelial cells PMID: 22805309
- Results indicate that WNT1-inducible signaling pathway protein 3 (WISP3) mutations are associated with progressive pseudorheumatoid dysplasia (PPD). PMID: 22685593
- CCN6 was highly expressed in end-stage osteoarthritic cartilage, suggesting a role in cartilage homeostasis. CCN6-induced repression of ADAMTS-5 and regulation of MMP-10 expression suggest complex roles for CCN6 in cartilage biology. PMID: 22294415
- The mutations of the WISP3 gene in Progressive pseudorheumatoid dysplasia are located in the range of exon 2 to exon 5. PMID: 21993478
- demonstrated that CCN6 induced the proliferation of lung fibroblasts by binding to integrin beta1, leading to the phosphorylation of FAK(Y397). PMID: 21921419
- our results indicate that CCN6 enhances the migration of chondrosarcoma cells by increasing ICAM-1 expression PMID: 21391218
- Data define a pathway in which CCN6 attenuates IGF-1 signaling to decrease ZEB1 expression and invasion in breast cancer. PMID: 21525039
- KLK12 may indirectly regulate the bioavailability and activity of several growth factors through processing of their CCN binding partners PMID: 21628462
- Homozygous recurring mutation in WISP3 causing progressive pseudorheumatoid arthropathy. PMID: 21528827
- The expressions of Cyr61 and/or WISP-3 may be important biological markers in reflecting the progression, biological behaviors, metastatic potential and prognosis of NSCLC. PMID: 21159247
- WISPs may play important but contrasting roles in colorectal cancer with WISP-1 appearing to act as a factor stimulating aggressiveness, WISP-2 as a tumour suppressor and WISP-3 having no definable beneficial or detrimental role PMID: 20372786
- CCN6 (WISP3) blockade activates growth factor-independent survival and resistance to anoikis in human mammary epithelial cells PMID: 20395207
- WISP3 and RhoC genes expression status defines a molecular signature of inflammatory breast cancer (IBC). PMID: 20014943
- WISP3 acts as a tumor suppressor gene in the breast. Loss of WISP3 expression contributes to the phenotype of IBC by regulating tumor cell growth, invasion and angiogenesis. PMID: 12082632
- WISP3 gene expression is higher in rheumatoid arthritis synovium and fibroblast-like synoviocytes compared with osteoarthritis and normal synovial tissue and is further induced by proinflammatory cytokines in vitro. PMID: 15517620
- the WISP3 gene is essential to skeletal growth or homeostasis in humans but not in mice PMID: 15601861
- WISP transcripts may have a role in the development of human hepatocellular carcinoma PMID: 15650268
- stable inhibition of CCN6 expression in human mammary epithelial cells induces epithelial-mesenchymal transition, promotes anchorage-independent growth, motility and invasiveness, and sensitizes mammary epithelial cells to the growth effects of IGF-1 PMID: 16457688
- WISP-3 may also promote superoxide dismutase expression and activity in chondrocytes PMID: 16480948
- WISP3 regulates the accumulation of cellular reactive oxygen species, and mutations in WISP3 or loss of expression of WISP3 compromise this function. PMID: 17286957
- Mutant WISP3 triggers the phenotype shift of articular chondrocytes by promoting sensitivity to IGF1 hypothesis of osteochondrodysplasias. PMID: 17363178
- WISP-3 showed no statistically significant difference between groups. PMID: 17406949
- Results show a compound heterozygous mutation of WISP3 and a series of cellular and molecular changes disturbing the endochondral ossification in this PPD patient. PMID: 17483925
- These results lead to a new hypothesis that Snail and ZEB1 are downstream of CCN6 and play a critical role in CCN6-mediated regulation of E-cadherin in breast cancer. PMID: 18321996
- novel G46X and C114Y mutations in exon 3 in WISP3 gene are responsible for PPD in Chinese patients PMID: 19064006
顯示更多
收起更多
-
相關(guān)疾病:Progressive pseudorheumatoid arthropathy of childhood (PPAC)
-
亞細(xì)胞定位:Secreted. Mitochondrion.
-
蛋白家族:CCN family
-
組織特異性:Predominant expression in adult kidney and testis and fetal kidney. Weaker expression found in placenta, ovary, prostate and small intestine. Also expressed in skeletally-derived cells such as synoviocytes and articular cartilage chondrocytes.
-
數(shù)據(jù)庫鏈接:
Most popular with customers
-
YWHAB Recombinant Monoclonal Antibody
Applications: ELISA, WB, IHC, IF, FC
Species Reactivity: Human, Mouse, Rat
-
Phospho-YAP1 (S127) Recombinant Monoclonal Antibody
Applications: ELISA, WB, IHC
Species Reactivity: Human
-
-
-
-
-
-